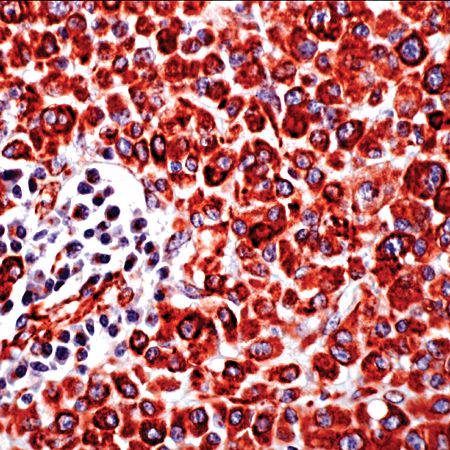

Vimentin (SP20)
Vimentin is the main intermediate filament protein in mesenchymal cells. This protein is believed to be involved with the intracellular transport of proteins between the nucleus and plasma membrane. Vimentin stains sarcomas of neural, muscle and fibroblast origin, but carcinomas which are generally negative. Melanomas, lymphomas and vascular tumors may all stain for Vimentin.
....Related Files